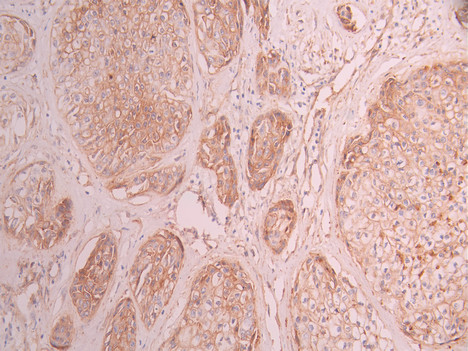

CAV2 Recombinant Monoclonal Antibody
-
中文名稱:CAV2 Recombinant Monoclonal Antibody
-
貨號:CSB-RA789994A0HU
-
規格:¥1320
-
圖片:
-
Western Blot
Positive WB detected in: A549 whole cell lysate(30μg), HEK293T whole cell lysate(30μg), Hela whole cell lysate(30μg), A431 whole cell lysate(30μg), MCF-7 whole cell lysate(30μg), U-251MG whole cell lysate(30μg)
All lanes: Caveolin 2 antibody at 1:1000
Secondary
Goat polyclonal to rabbit IgG at 1/40000 dilution
Predicted band size: 18 kDa
Observed band size: 18 kDa
Exposure time:40s -
IHC image of CSB-RA789994A0HU diluted at 1:100 and staining in paraffin-embedded human pancreatic cancer performed on a Leica BondTM system. After dewaxing and hydration, antigen retrieval was mediated by high pressure in a citrate buffer (pH 6.0). Section was blocked with 10% normal goat serum 30min at RT. Then primary antibody (1% BSA) was incubated at 4°C overnight. The primary is detected by a Goat anti-rabbit polymer IgG labeled by HRP and visualized using 0.05% DAB.
-
Immunofluorescence staining of A431 cell with CSB-RA789994A0HU at 1:50, counter-stained with DAPI. The cells were fixed in 4% formaldehyde and blocked in 10% normal Goat Serum. The cells were then incubated with the antibody overnight at 4°C. The secondary antibody was Alexa Fluor 488-congugated AffiniPure Goat Anti-Rabbit IgG(H+L).
-
Overlay Peak curve showing 786-O cells stained with CSB-RA789994A0HU (red line) at 1:100. The cells were fixed in 4% formaldehyde and permeated by 0.2% TritonX-100 for 10min. Then 10% normal goat serum to block non-specific protein-protein interactions followed by the antibody (1ug/1*106cells) for 45min at 4℃. The secondary antibody used was FITC-conjugated goat anti-rabbit IgG (H+L) at 1/200 dilution for 35min at 4℃.Control antibody (green line) was Rabbit IgG (1ug/1*106cells) used under the same conditions. Acquisition of >10,000 events was performed.
-
-
其他:
產品詳情
-
Uniprot No.:
-
基因名:
-
別名:Caveolin-2, CAV2
-
反應種屬:Human
-
免疫原:A synthesized peptide from human CAV2 protein
-
免疫原種屬:Homo sapiens (Human)
-
標記方式:Non-conjugated
-
克隆類型:Monoclonal
-
抗體亞型:Rabbit IgG
-
純化方式:Affinity-chromatography
-
克隆號:11D4
-
濃度:It differs from different batches. Please contact us to confirm it.
-
保存緩沖液:Preservative: 0.03% Proclin 300
Constituents: 50% Glycerol, 0.01M PBS, PH 7.4 -
產品提供形式:Liquid
-
應用范圍:ELISA, WB, IHC, IF, FC
-
推薦稀釋比:
Application Recommended Dilution WB 1:500-1:2000 IHC 1:50-1:200 IF 1:50-1:200 FC 1:50-1:200 -
Protocols:
-
儲存條件:Upon receipt, store at -20°C or -80°C. Avoid repeated freeze.
-
貨期:Basically, we can dispatch the products out in 1-3 working days after receiving your orders. Delivery time maybe differs from different purchasing way or location, please kindly consult your local distributors for specific delivery time.
-
用途:For Research Use Only. Not for use in diagnostic or therapeutic procedures.
相關產品
靶點詳情
-
功能:May act as a scaffolding protein within caveolar membranes. Interacts directly with G-protein alpha subunits and can functionally regulate their activity. Acts as an accessory protein in conjunction with CAV1 in targeting to lipid rafts and driving caveolae formation. The Ser-36 phosphorylated form has a role in modulating mitosis in endothelial cells. Positive regulator of cellular mitogenesis of the MAPK signaling pathway. Required for the insulin-stimulated nuclear translocation and activation of MAPK1 and STAT3, and the subsequent regulation of cell cycle progression.
-
基因功能參考文獻:
- Cav-2beta isoform yielded by alternative translation initiation desensitizes insulin receptor (IR) via dephosphorylation by PTP1B, and subsequent endocytosis and lysosomal degradation of IR, causing insulin resistance. PMID: 29604334
- Results verified the presence of transcript III of cav-2 for the first time, but no protein associated was found. Also, a decreasing trend of cav-2 (transcripts I and II) were observed in tumoral tissues especially in stages I and II and seem to be associated with the incidence and promotion of breast cancer, especially in the initial stages of breast cancer. PMID: 28857238
- High CAV2 expression is associated with lung cancer. PMID: 26930711
- A-type lamin-dependent Caveolin-2 homo-oligomerization in the inner nuclear membrane microdomain is a precondition for pY19-Caveolin-2-mediated insulin-response epigenetic activation at the nuclear periphery. PMID: 27552914
- Caveolin-2 expression is necessary for the control of E2-dependent cellular proliferation of MCF-7 cells. PMID: 26480297
- variant in CAV2 is associated with increased age-of-onset of P. aeruginosa airway infection in cystic fibrosis cohort. PMID: 26047157
- Results present initial characterization of key proteins Cav2 and CFL1 as cellular factors that colocalize with M in viral inclusions and filaments and ZNF502 protein which appears to interact with RSV M in the nucleus. PMID: 25556234
- Our findings did not correspond with previous positive results, suggesting that CAV1-CAV2 variants studied in the present study are not important risk factors for Normal Tension Glaucoma. PMID: 23743525
- This study does not support an association between CAV2 variation and kidney transplant survival. PMID: 23667606
- The combination of the expression of the genes for PPARgamma, STMN1 and CAV2 was significantly predictive for early recurrence of non-muscle-invasive bladder cancer PMID: 21489836
- In contrast to wild-type-Cav-2, retroviral re-expression of Y19/27F-Cav-2 in Cav-2 knockout endothelial cells did not affect anti-proliferative effect of TGF-beta compared to empty vector. PMID: 22819829
- Stromal caveolin-2 expression were more frequent in anaplastic carcinoma and diffuse sclerosing variant of papillary carcinoma compared to conventional papillary thyroid carcinoma. PMID: 22236542
- CAV1 mRNA and protein levels are reduced by both NFBD1 knockdown and knockout independently of IR and p53 PMID: 21551225
- cav-2 acts as a modulator of cancer progression. PMID: 21373752
- We found preliminary evidence that CAV2 rs2270188 interacts with dietary fat to affect risk of type 2 diabetes. PMID: 21178094
- Single Nucleotide Polymorphisms in CAV2 is associated with primary open-angle glaucoma. PMID: 20835238
- In Caco-2 cells, a polarized cell line derived from human colon cancer that does not express caveolin 1 (Cav-1), there was no detectable expression of caveolin 2 (Cav-2). PMID: 12414992
- caveolin-2 may play a role in lamellar granule assembly, trafficking, and/or function. PMID: 12648214
- PPARgamma ligands increased the levels of caveolin-2 2-5-fold in a concentration-dependent manner within 24 h. Nonthiazolidinedione PPARgamma ligands elevated caveolin-2 protein 3-4-fold. PMID: 12813462
- New evidence demonstrating that Cav-2 undergoes phosphorylation at both tyrosines 19 and 27 also reveals that tyrosine phosphorylation of Cav-2 has no effect on its targeting to lipid rafts, but clearly disrupts hetero-oligomerization of Cav-2 with Cav-1. PMID: 15504032
- Heterologously and endogenously expressed D1 dopamine receptors in renal cells are associated with and regulated by caveolin-2. PMID: 15569306
- Overexpression of caveolin-2 is associated with inflammatory breast cancer PMID: 16244790
- CAV2 identified and immunolocalized in the caveola-vesicle complexes (CVC )present in erythrocytes infected with P. vivax PMID: 16521037
- Caveolin-2 was expressed in the sinusoidal endothelial cells and the smooth muscle cells of the unparied arteries of hepatpcellular carcinoma specimens. PMID: 17898556
- CAV2 is preferentially expressed in basal-like cancers and is associated with poor prognosis PMID: 17912630
- Data suggests a possible involvement of serine 36-phosphorylated caveolin-2 in modulating mitosis. PMID: 18081315
顯示更多
收起更多
-
亞細胞定位:Nucleus. Cytoplasm. Golgi apparatus membrane; Peripheral membrane protein. Cell membrane; Peripheral membrane protein. Membrane, caveola; Peripheral membrane protein.
-
蛋白家族:Caveolin family
-
組織特異性:Expressed in endothelial cells, smooth muscle cells, skeletal myoblasts and fibroblasts.
-
數據庫鏈接:
Most popular with customers
-
-
YWHAB Recombinant Monoclonal Antibody
Applications: ELISA, WB, IHC, IF, FC
Species Reactivity: Human, Mouse, Rat
-
Phospho-YAP1 (S127) Recombinant Monoclonal Antibody
Applications: ELISA, WB, IHC
Species Reactivity: Human
-
-
-
-
-